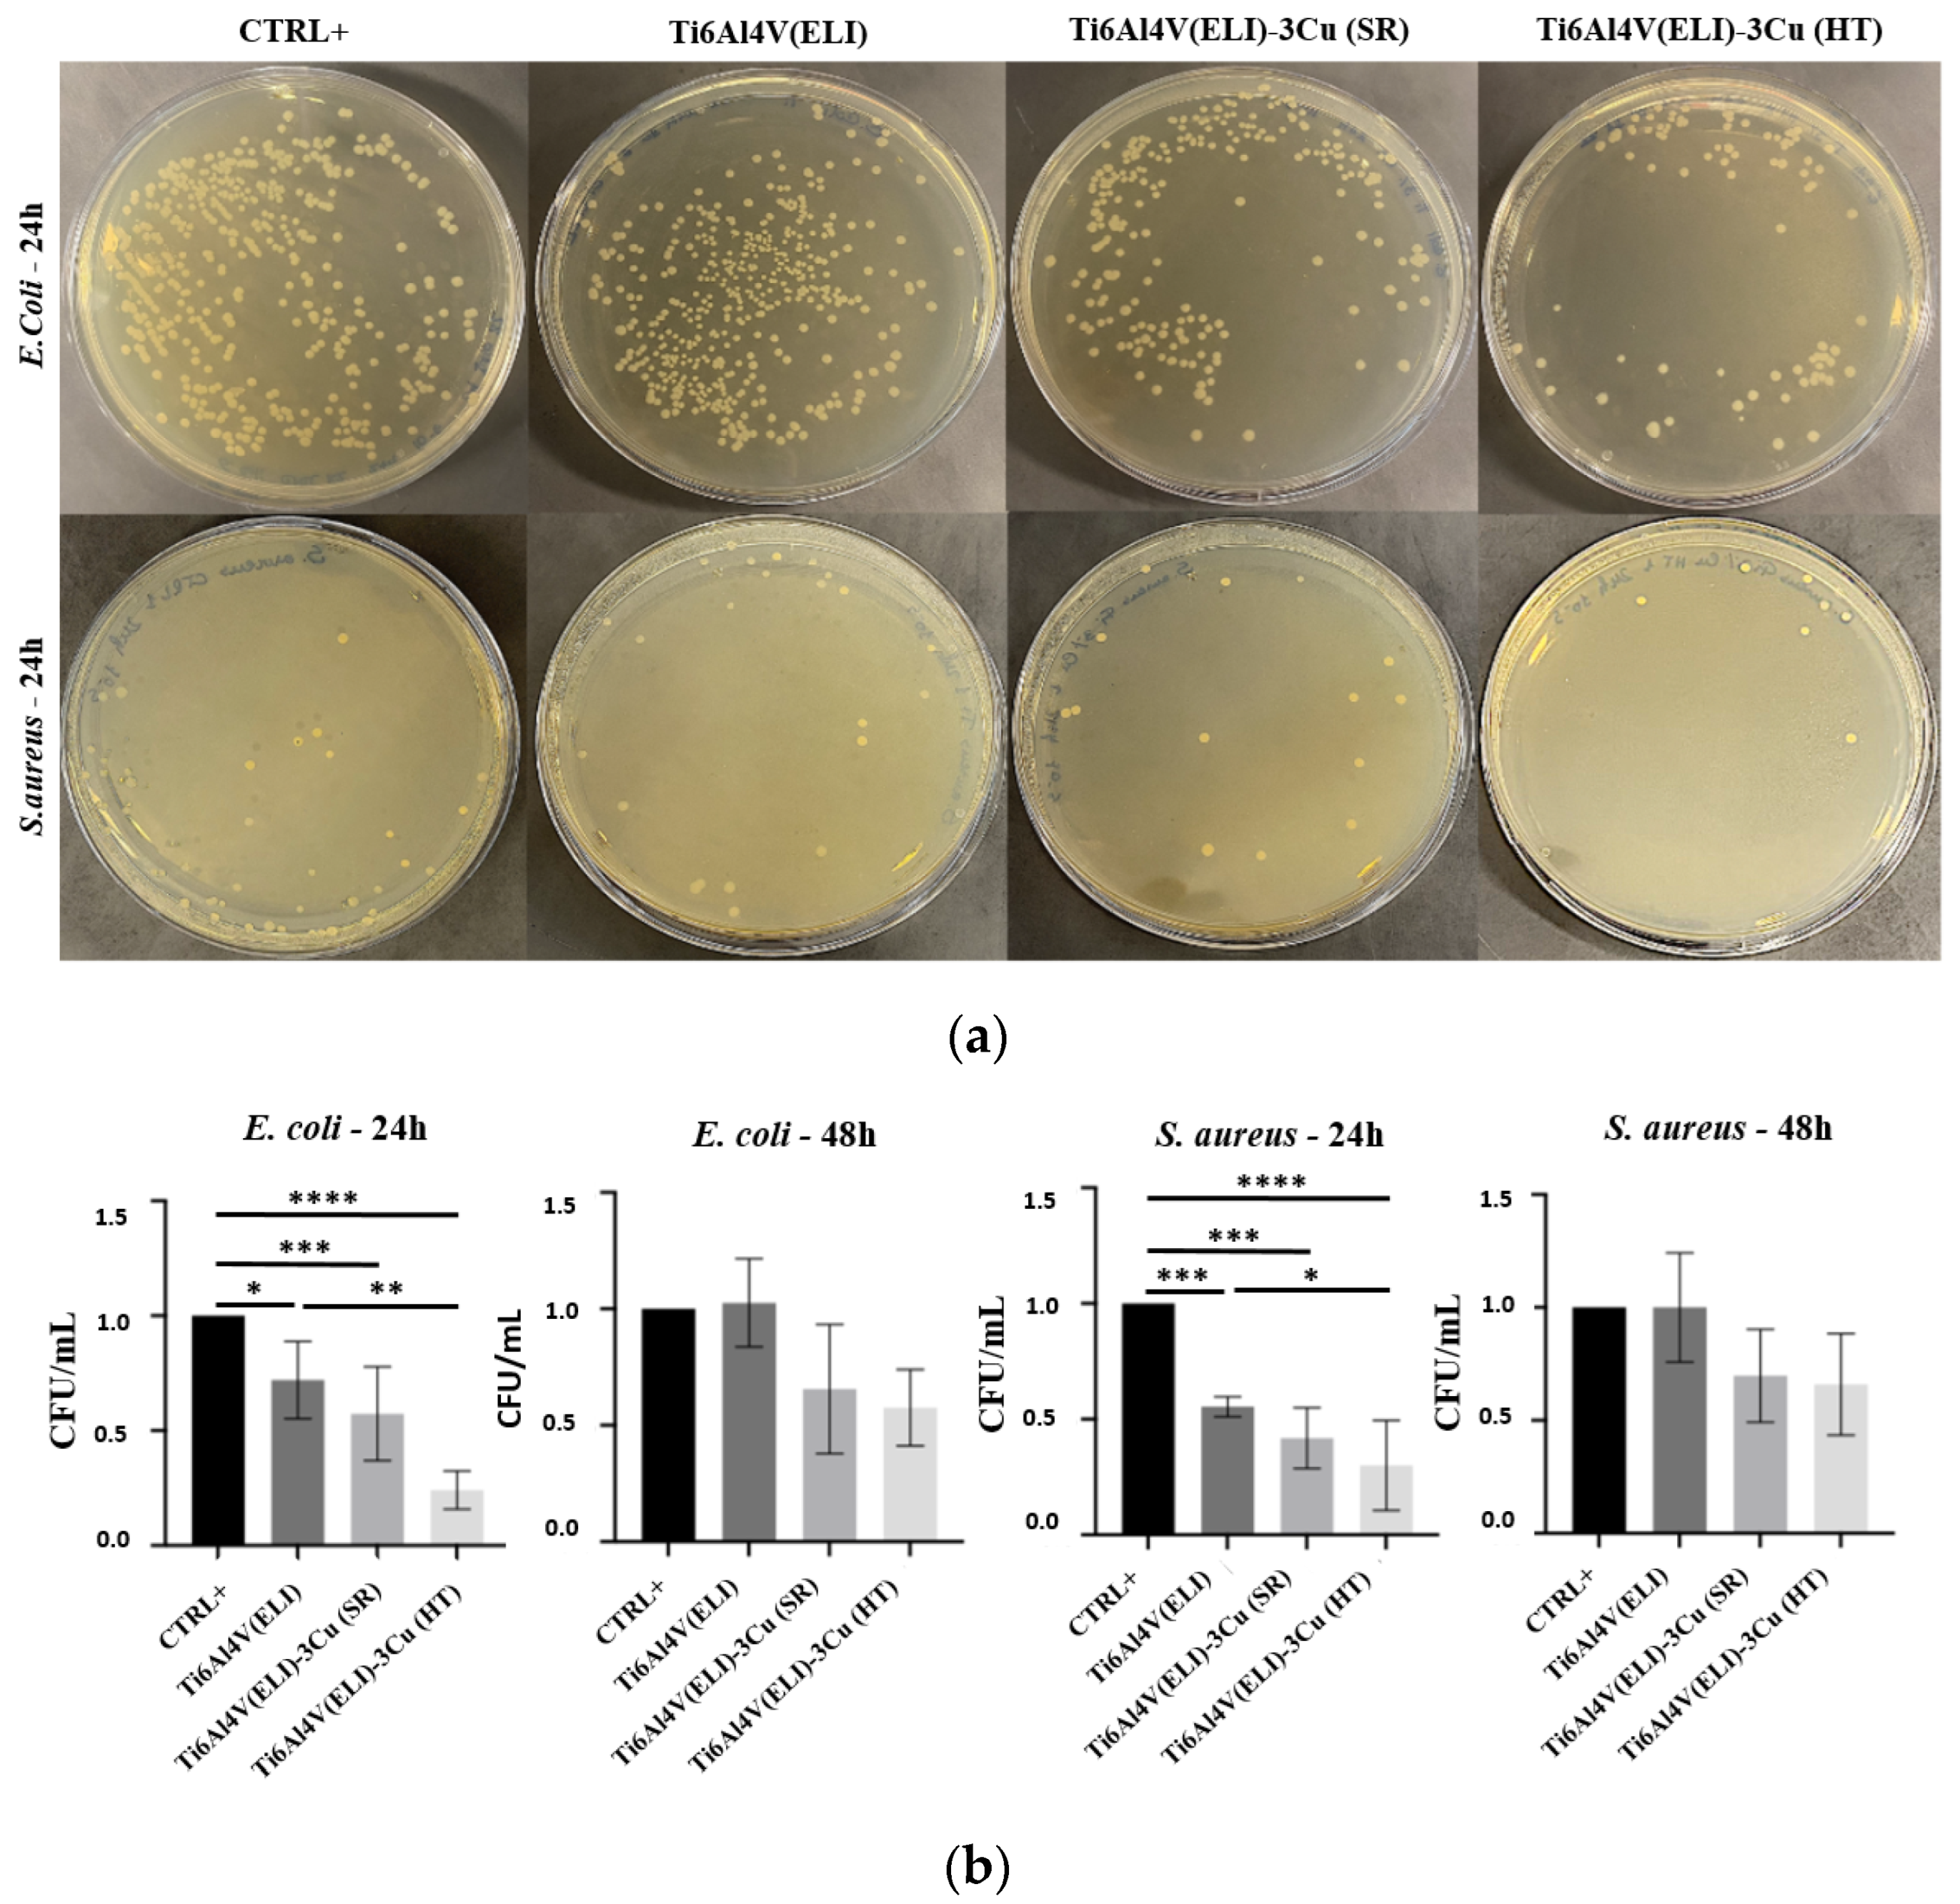
Jfb 14 00063 g010

Effect of Heat Treatment on Osteoblast Performance and Bactericidal Behavior of Ti6Al4V(ELI)-3at.%Cu Fabricated by Laser Powder Bed Fusion
Abstract
1. Introduction
2. Materials and Methods
2.1. Sample Preparation
2.2. Microstructural Characterization
2.3. Osteoblast Culture
2.4. Osteoblast Viability and Proliferation
2.5. Osteoblast Mineralization Assessment
2.6. Osteoblast Morphology
2.7. Bacterial Culture Preparation
2.8. Antibacterial Effect by Ion Diffusion
2.9. Inhibition of Biofilm Formation
2.10. Statistical Analysis
3. Results
3.1. Microstructural Analyses
3.2. Osteoblast Assessment
3.2.1. Evaluation of Cell Viability and Proliferation
3.2.2. Osteoblast Mineralization
3.2.3. Osteoblast Morphology
3.3. Bactericidal Assessment
3.3.1. Evaluation of the Antibacterial Effect of Cu by Ion Diffusion
3.3.2. Inhibition of Biofilm Formation
4. Discussion
4.1. Microstructural Analysis
4.2. Osteoblast Behavior
4.3. Bactericidal Behavior
5. Conclusions
Author Contributions
Funding
Institutional Review Board Statement
Informed Consent Statement
Data Availability Statement
Acknowledgments
Conflicts of Interest
References
- Goldring, S.R.; Goldring, M.B. Changes in the osteochondral unit during osteoarthritis: Structure, function and cartilage bone crosstalk. Nat. Rev. Rheumatol. 2016, 12, 632–644. [Google Scholar] [CrossRef]
- Whittaker, J.L.; Truong, L.K.; Dhiman, K.; Beck, C. Osteoarthritis Year in Review 2020: Rehabilitation and Outcomes. Osteoarthr Cartilage. 2021, 29, 190–207. [Google Scholar] [CrossRef] [PubMed]
- Liu, J.; Liu, J.; Attarilar, S.; Wang, C.; Tamaddon, M.; Yang, C.; Xie, K.; Yao, J.; Wang, L.; Liu, C.; et al. Nano-Modified Titanium Implant Materials: A Way Toward Improved Antibacterial Properties. Front. Bioeng. Biotechnol. 2020, 8, 576969. [Google Scholar] [CrossRef]
- Marin, M.; Esteban, J.; Meseguer, M.A.; Sanchez-Somolinos, M. Diagnostico microbiologico de las infecciones osteoarticulares. Enferm. Infect. Microbiol. Clin. 2010, 28, 534–540. [Google Scholar] [CrossRef]
- Donlan, R.M.; Costerton, J.W. Biofilms: Survival mechanisms of clinically relevant microorganisms. Clin. Microbiol. Rev. 2002, 15, 167–193. [Google Scholar] [CrossRef]
- Vilardell, A.M.; Krakhmalev, P.; Yadroitsava, I.; Yadroitsev, I.; Garcia-Giralt, N. In Vitro Characterization of In Situ Alloyed Ti6Al4V(ELI)-3 at.% Cu Obtained by Laser Powder Bed Fusion. Materials 2021, 14, 7260. [Google Scholar] [CrossRef] [PubMed]
- Vincent, M.; Duval, R.E.; Hartemann, P.; Engels-Deutsch, M. Contact killing and antimicrobial properties of copper. J. Appl. Microbiol. 2018, 124, 1032–1046. [Google Scholar] [CrossRef] [PubMed]
- Zhang, E.; Zhao, X.; Hu, J.; Wang, R.; Fu, S.; Qin, G. Antibacterial metals and alloys for potential biomedical implants. Bioact. Mater. 2021, 6, 2569–2612. [Google Scholar] [CrossRef]
- Frazier, W.E. Metal Additive Manufacturing: A Review. J. Mater. Eng. Perform. 2014, 23, 1917–1928. [Google Scholar] [CrossRef]
- Liu, S.; Shin, Y.C. Additive manufacturing of Ti6Al4V alloy: A review. Mater. Des. 2019, 164, 107552. [Google Scholar] [CrossRef]
- Bauer, S.; Schmuki, P.; von der Mark, K.; Park, J. Engineering biocompatible implant surfaces: Part I: Materials and surfaces. Prog. Mater. Sci. 2013, 58, 261–326. [Google Scholar] [CrossRef]
- Vilardell, A.M.; Yadroitsev, I.; Yadroitsava, I.; Albu, M.; Takata, N.; Kobashi, M.; Krakhmalev, P.; Kouprianoff, D.; Kothleitner, G.; Du Plessis, A. Manufacturing and characterization of in-situ alloyed Ti6Al4V(ELI)-3 at.% Cu by laser powder bed fusion. Addit. Manuf. 2020, 36, 101436. [Google Scholar] [CrossRef]
- Ma, Z.; Liu, R.; Zhao, Y.; Ren, L.; Yang, K. Study on the antibacterial mechanism of Cu-bearing titanium alloy in the view of materials science. Mater. Technol. 2020, 35, 11–20. [Google Scholar] [CrossRef]
- Liu, J.; Li, F.; Liu, C.; Wang, H.; Ren, B.; Yang, K.; Zhang, E. Effect of Cu content on the antibacterial activity of titanium–copper sintered alloys. Mater. Sci. Eng. C 2014, 35, 392–400. [Google Scholar] [CrossRef] [PubMed]
- Guo, S.; Lu, Y.; Wu, S.; Liu, L.; He, M.; Zhao, C.; Gan, Y.; Lin, J.; Luo, J.; Xu, X.; et al. Preliminary study on the corrosion resistance, antibacterial activity and cytotoxicity of selective-laser-melted Ti6Al4V-xCu alloys. Mater. Sci. Eng. C Mater. Biol. Appl. 2017, 72, 631–640. [Google Scholar] [CrossRef] [PubMed]
- Krakhmalev, P.; Yadroitsev, I.; Yadroitsava, I.; de Smidt, O. Functionalization of Biomedical Ti6Al4V via In Situ Alloying by Cu during Laser Powder Bed Fusion Manufacturing. Materials 2017, 10, 1154. [Google Scholar] [CrossRef]
- Zhuang, Y.; Ren, L.; Zhang, S.; Wei, X.; Yang, K.; Dai, K. Antibacterial effect of a copper-containing titanium alloy against implant-associated infection induced by methicillin-resistant Staphylococcus aureus. Acta. Biomater. 2021, 119, 472–484. [Google Scholar] [CrossRef]
- Ma, Z.; Ren, L.; Liu, R.; Yang, K.; Zhang, Y.; Liao, Z.; Liu, W.; Qi, M.; Misra, R. Effect of Heat Treatment on Cu Distribution, Antibacterial Performance and Cytotoxicity of Ti–6Al–4V–5Cu Alloy. J. Mater. Sci. Technol. 2015, 31, 723–732. [Google Scholar] [CrossRef]
- Vilardell, A.M.; Takezawa, A.; Du Plessis, A.; Takata, N.; Krakhmalev, P.; Kobashi, M.; Albu, M.; Kothleitner, G.; Yadroitsava, I.; Yadroitsev, I. Mechanical behavior of in-situ alloyed Ti6Al4V(ELI)-3 at.% Cu lattice structures manufactured by laser powder bed fusion and designed for implant applications. J. Mech. Behav. Biomed. Mater. 2021, 113, 104130. [Google Scholar] [CrossRef]
- Peng, C.; Zhang, S.; Sun, Z.; Ren, L.; Yang, K. Effect of annealing temperature on mechanical and antibacterial properties of Cu-bearing titanium alloy and its preliminary study of antibacterial mechanism. Mater. Sci. Eng. C Mater. Biol. Appl. 2018, 93, 495–504. [Google Scholar] [CrossRef]
- Peng, C.; Liu, Y.; Liu, H.; Zhang, S.; Bai, C.; Wan, Y.; Ren, L.; Yang, K. Optimization of annealing treatment and comprehensive properties of Cu-containing Ti6Al4V-xCu alloys. J. Mater. Sci. Technol. 2019, 35, 2121–2131. [Google Scholar] [CrossRef]
- Vilardell, A.M.; Takezawa, A.; Du Plessis, A.; Takata, N.; Krakhmalev, P.; Kobashi, M.; Yadroitsava, I.; Yadroitsev, I. Topology optimization and characterization of Ti6Al4V ELI cellular lattice structures by laser powder bed fusion for biomedical applications. Mater. Sci. Eng. A 2018, 766, 138330. [Google Scholar] [CrossRef]
- Schlossmacher, P.; Klenov, D.O.; Freitag, B.; von Harrach, H.S. Enhanced detection sensitivity with a new windowless XEDS system for AEM based on silicon drift detector technology. Microsc. Today 2010, 18, 14–20. [Google Scholar] [CrossRef]
- Goldstein, J.I.; Williams, D.B.; Cliff, G. Quantification of energy dispersive spectra. In Principles of Analytical Electron Microscopy; Joy, D.C., Romig, A.D., Goldstein, J.L., Eds.; Plenum Press: New York, NY, USA, 1986; pp. 155–217. [Google Scholar]
- Nàcher, M.; Aubia, J.; Serrano, S.; Mariñoso, M.L.I.; Hernández, J.; Bosch, J.; Díez, A.; Puig, J.M.; Lloveras, J. Effect of cyclosporine A on normal human osteoblasts in vitro. Bone Miner. 1994, 26, 231–243. [Google Scholar] [CrossRef]
- Schindelin, J.; Arganda-Carreras, I.; Frise, E.; Kaynig, V.; Longair, M.; Pietzsch, T.; Preibisch, S.; Rueden, C.; Saalfeld, S.; Schmid, B.; et al. Fiji: An open-source platform for biological-image analysis. Nat. Methods 2012, 9, 676–682. [Google Scholar] [CrossRef] [PubMed]
- Yadroitsev, I.; Krakhmalev, P.; Yadroitsava, I.; Du Plessis, A. Qualification of Ti6Al4V ELI Alloy Produced by Laser Powder Bed Fusion for Biomedical Applications. JOM 2018, 70, 372–377. [Google Scholar] [CrossRef]
- Vrancken, B.; Thijs, L.; Kruth, J.-P.; van Humbeeck, J. Heat treatment of Ti6Al4V produced by Selective Laser Melting: Microstructure and mechanical properties. J. Alloys Compd. 2012, 541, 177–185. [Google Scholar] [CrossRef]
- Fowler, L.; Engqvist, H.; Öhman-Mägi, C. Effect of Copper Ion Concentration on Bacteria and Cells. Materials 2019, 12, 3798. [Google Scholar] [CrossRef]
- Xu, X.; Lu, Y.; Li, S.; Guo, S.; He, M.; Luo, K.; Lin, J. Copper-modified Ti6Al4V alloy fabricated by selective laser melting with pro-angiogenic and anti-inflammatory properties for potential guided bone regeneration applications. Mater. Sci. Eng. C 2018, 90, 198–210. [Google Scholar] [CrossRef] [PubMed]
- Duan, J.-Z.; Yang, Y.; Wang, H. Effects of Antibacterial Co-Cr-Mo-Cu Alloys on Osteoblast Proliferation, Differentiation, and the Inhibition of Apoptosis. Orthop. Surg. 2022, 14, 758–768. [Google Scholar] [CrossRef]
- Szczęsny, G.; Kopec, M.; Politis, D.J.; Kowalewski, Z.L.; Łazarski, A.; Szolc, T. A Review on Biomaterials for Orthopaedic Surgery and Traumatology: From Past to Present. Materials 2022, 18, 3622. [Google Scholar] [CrossRef] [PubMed]
- Wang, J.; Zhou, H.; Guo, G.; Cheng, T.; Peng, X.; Mao, X.; Li, J.; Zhang, X. A functionalized surface modification with vanadium nanoparticles of various valences against implant-associated bloodstream infection. Int. J. Nanomed. 2017, 12, 3121–3136. [Google Scholar] [CrossRef] [PubMed]

Disclaimer/Publisher’s Note: The statements, opinions and data contained in all publications are solely those of the individual author(s) and contributor(s) and not of MDPI and/or the editor(s). MDPI and/or the editor(s) disclaim responsibility for any injury to people or property resulting from any ideas, methods, instructions or products referred to in the content. |
© 2023 by the authors. Licensee MDPI, Basel, Switzerland. This article is an open access article distributed under the terms and conditions of the Creative Commons Attribution (CC BY) license (https://creativecommons.org/licenses/by/4.0/).
Share and Cite
Martín Vilardell, A.; Cantillo Alzamora, V.; Bauso, L.V.; Madrid, C.; Krakhmalev, P.; Albu, M.; Yadroitsava, I.; Yadroitsev, I.; Garcia-Giralt, N. Effect of Heat Treatment on Osteoblast Performance and Bactericidal Behavior of Ti6Al4V(ELI)-3at.%Cu Fabricated by Laser Powder Bed Fusion. J. Funct. Biomater. 2023, 14, 63. https://doi.org/10.3390/jfb14020063
Martín Vilardell A, Cantillo Alzamora V, Bauso LV, Madrid C, Krakhmalev P, Albu M, Yadroitsava I, Yadroitsev I, Garcia-Giralt N. Effect of Heat Treatment on Osteoblast Performance and Bactericidal Behavior of Ti6Al4V(ELI)-3at.%Cu Fabricated by Laser Powder Bed Fusion. Journal of Functional Biomaterials. 2023; 14(2):63. https://doi.org/10.3390/jfb14020063
Chicago/Turabian StyleMartín Vilardell, Anna, Vanesa Cantillo Alzamora, Luana Vittoria Bauso, Cristina Madrid, Pavel Krakhmalev, Mihaela Albu, Ina Yadroitsava, Igor Yadroitsev, and Natalia Garcia-Giralt. 2023. "Effect of Heat Treatment on Osteoblast Performance and Bactericidal Behavior of Ti6Al4V(ELI)-3at.%Cu Fabricated by Laser Powder Bed Fusion" Journal of Functional Biomaterials 14, no. 2: 63. https://doi.org/10.3390/jfb14020063
APA StyleMartín Vilardell, A., Cantillo Alzamora, V., Bauso, L. V., Madrid, C., Krakhmalev, P., Albu, M., Yadroitsava, I., Yadroitsev, I., & Garcia-Giralt, N. (2023). Effect of Heat Treatment on Osteoblast Performance and Bactericidal Behavior of Ti6Al4V(ELI)-3at.%Cu Fabricated by Laser Powder Bed Fusion. Journal of Functional Biomaterials, 14(2), 63. https://doi.org/10.3390/jfb14020063

